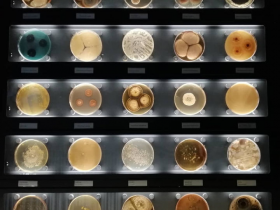
几种常见传染病及检测工具

埃博拉(Ebola virus)又译作伊波拉病毒。是一种十分罕见的病毒,1976年在苏丹南部和刚果(金)(旧称扎伊尔)的埃博拉河地区发现它的存在后,引起医学界的广泛关注和重视,“埃博拉”由此而得名。是一个用来称呼一群属于纤维病毒科埃博拉病毒属下数种病毒的通用术语。是一种能引起人类和灵长类动物产生埃博拉出血热的烈性传染病病毒,有很高的死亡率,在50%至90%之间,致死原因主要为中风、心肌梗塞、低血容量休克或多发性器官衰竭。

遏制埃博拉等新发再发传染性疾病的暴发和流行,有赖于高效、可及的医学干预防治手段。但到目前为止,尚未有针对埃博拉病毒的特异性治疗药物和预防性疫苗正式上市。
中科院广州生物医药与健康研究院和广州医科大学联合共建的呼吸疾病国家重点实验室,与清华大学等单位合作,通过单细胞克隆等技术,成功从猕猴体内分离出我国首例抗埃博拉病毒感染的高效单克隆中和抗体。相关研究5月17日在线发表于《科学报告》。
据了解,研究人员已从免疫的猕猴体内分离出3株具高中和能力、高度人源化的抗埃博拉病毒的单克隆抗体,并与加拿大公共卫生局教授邱香果合作,通过感染埃博拉活病毒的动物保护实验,证明其中两个抗体在小鼠感染埃博拉活病毒48小时后,具有很强的保护作用。
该研究组利用该平台技术得到的抗体,因为免疫细胞经过多次抗原刺激逐步成熟,抗体基因发生高频突变最终使亲和力不断提高,从而能更有效地阻断病原体感染;同时,由于猕猴与人抗体基因的高度同源性,而且最终得到的恒河猴抗体可变区与人源抗体恒定区组合为嵌合抗体后,与纯人源抗体完全相似,使其临床应用前景相对其他动物来源的抗体更为开阔。
在新发突发传染病发生时且无康复者提供免疫细胞用于找寻高效价中和抗体时,使用该策略应对急性新发传染性疾病可迅速找到候选中和抗体用于临床救治。